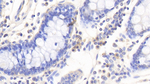
IL-12 p40 Antibody in Immunohistochemistry (Paraffin) (IHC (P))

Search
Invitrogen
IL-12 p40 Monoclonal Antibody (C16)
{{$productOrderCtrl.translations['antibody.pdp.commerceCard.promotion.promotions']}}
{{$productOrderCtrl.translations['antibody.pdp.commerceCard.promotion.viewpromo']}}
{{$productOrderCtrl.translations['antibody.pdp.commerceCard.promotion.promocode']}}: {{promo.promoCode}} {{promo.promoTitle}} {{promo.promoDescription}}. {{$productOrderCtrl.translations['antibody.pdp.commerceCard.promotion.learnmore']}}
图: 1 / 3
IL-12 p40 Antibody (MA566099) in IHC (P)

Please note: We are reviewing Western blot images included in the antibody testing data in our catalog, including those provided by third parties. Unless expressly labeled or annotated as “raw-unedited”, Western blot images included in the antibody testing data in our catalog may have been edited, optimized or otherwise adjusted for presentation.
产品信息
MA566099
种属反应
宿主/亚型
分类
类型
克隆号
抗原
偶联物
形式
浓度
规格
纯化类型
保存液
内含物
保存条件
运输条件
RRID
靶标信息
IL12B (IL-12 p40) encodes a subunit of interleukin 12, a cytokine that acts on T and natural killer cells, and has a broad array of biological activities. Interleukin 12 is a disulfide-linked heterodimer composed of the 40 kDa cytokine receptor like subunit encoded by this gene, and a 35 kDa subunit encoded by IL12A. This cytokine is expressed by activated macrophages that serve as an essential inducer of Th1 cells development. This cytokine has been found to be important for sustaining a sufficient number of memory/effector Th1 cells to mediate long-term protection to an intracellular pathogen. Overexpression of this gene was observed in the central nervous system of patients with multiple sclerosis (MS), suggesting a role of this cytokine in the pathogenesis of the disease. The promoter polymorphism of this gene has been reported to be associated with the severity of atopic and non-atopic asthma in children.
仅用于科研。不用于诊断过程。未经明确授权不得转售。
篇参考文献 (0)
生物信息学
蛋白别名: CLMF p35; CLMF p40; Cytotoxic lymphocyte maturation factor 40 kDa subunit; IL-12 subunit p35; IL-12 subunit p40; IL-12A; IL-12B; IL12 p40; IL12A; Interleukin; interleukin 12B (natural killer cell stimulatory factor 2, cytotoxic lymphocyte maturation factor 2, p40); interleukin-12 p40 subunit; Interleukin-12 subunit beta; interleukin-23 p40 subunit; NK cell stimulatory factor chain 2; NKSF1; NKSF2; RP23-388G23.1
基因别名: IL12B; NKSF2
UniProt ID: (Pig) Q28938
Entrez Gene ID: (Pig) 397076




